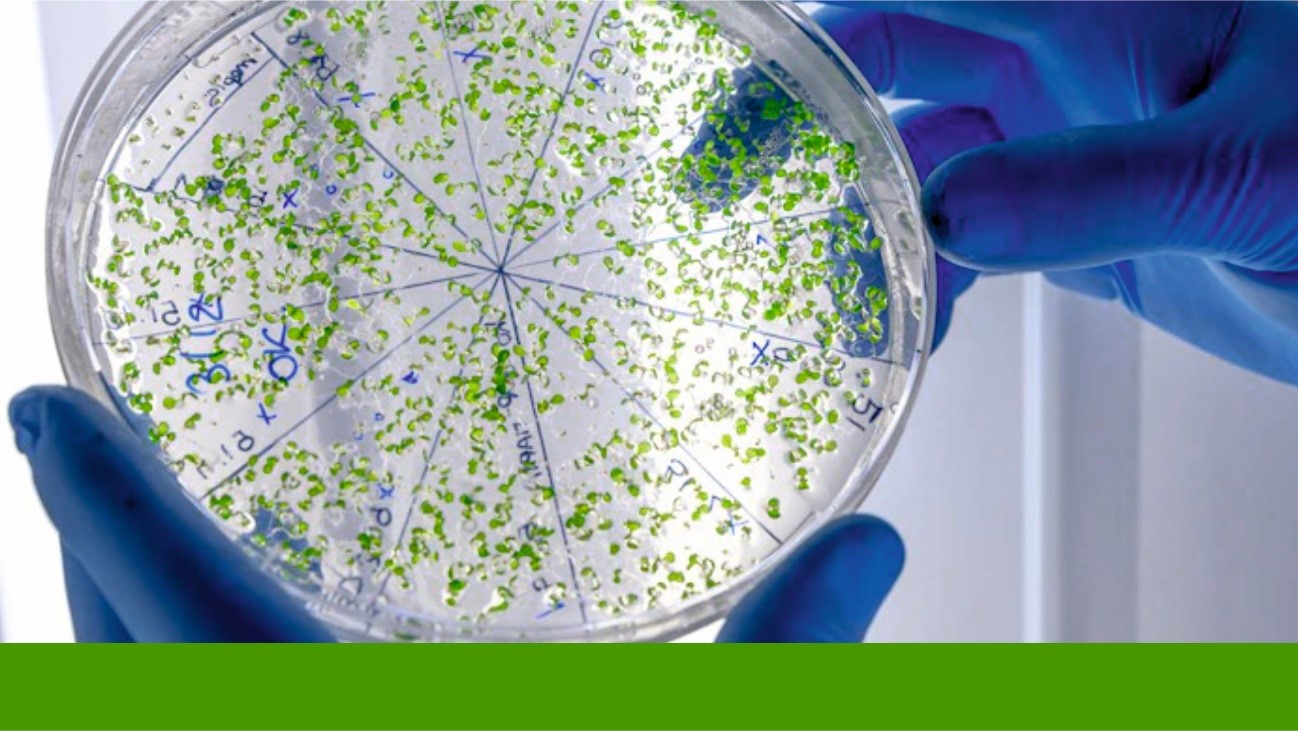

A tecnologia e pesquisa aplicada ao setor agro comprovam que os muitos microrganismos são essenciais para uma boa saúde dos solos, sanidade e desenvolvimento das plantas, impactando diretamente na produtividade dos cultivos
Por muito tempo os microrganismos foram vistos como vilões da agricultura por serem relacionados como agentes causadores de doenças nas plantas, porém, com os passar dos anos e graças aos avanços da tecnologia e das pesquisas focadas no entendimento destes seres microscópicos, essa visão vem mudando drasticamente.
Hoje é possível dizer que a maioria dos organismos não causam nenhum tipo de patologia nas plantas, pelo contrário, proporcionam ainda benefícios para o ecossistema como um todo, do solo ao alimento final produzido.
O que são os microrganismos?
Antes de aprofundarmos sobre os benefícios que os microrganismos oferecem às plantas, é importante conhecermos um pouco mais sobre eles.
A vida surgiu na Terra há mais de 4 bilhões de anos na forma de microrganismos e, desde então, esses seres vêm evoluindo em inúmeras espécies e cepas. “São os seres vivos mais diversos e abundantes do planeta e nós, de fato, vivemos no mundo deles e eles vivem em nós”, afirma Johana Perez, Gerente Global de Design de Produto de P&D da Rovensa Next no Brasil.
Temos mais de 8 bilhões de pessoas no mundo e cada um de nós carrega em nosso corpo mais de 100 trilhões de microrganismos, dos quais a vasta maioria forma associações benéficas que impactam positivamente nosso organismo, viabilizando o funcionamento pleno do corpo, participando de processo como a digestão e modulando nosso sistema imune, até o nosso humor. Johana afirma que nenhum ser humano consegue viver sem os microrganismos.
Os microrganismos são representados por:
- Vírus
- Bactérias
- Protozoários
- Fungos
Ação dos microrganismos nas plantas
Assim como são importantes para os seres humanos, os microrganismos também são benéficos com as plantas. Segundo Johana, um único grama de solo carrega bilhões de microrganismos que formam associações, em sua maioria, benéficas com as plantas, como por exemplo, ajudam na captura de nutrientes essenciais, além de combaterem micro e macroorganismos inimigos.
“A ciência não conhecia muito destes micróbios até recentemente, pois são seres difíceis de serem estudados por realizarem o seu trabalho de forma tão silenciosa que passam despercebidos”, explica Johana.
As novas tecnologias de biologia molecular, como o sequenciamento genético de nova geração (Next Generation Sequencing), usadas apenas há um par de décadas, ajudaram a identificar milhares desses microrganismos e desvendar sua função na rizosfera e na parte aérea das plantas.
Importância dos microrganismos na agricultura
Hoje os microrganismos são aliados dos produtores rurais sendo usados para fixação biológica do nitrogênio, solubilização do fósforo e como agentes de controle de pragas e doenças. Atualmente, diversas espécies de microrganismos são utilizadas na agricultura, sendo os mais antigos os fixadores biológicos de nitrogênio, como o Bradyhizobium, que é aplicado na cultura da soja há mais de 100 anos.
Johana Perez explica que estes tipos de microrganismos são conhecidos como endofíticos (dentro da planta) e os mais utilizados na agricultura são os rizóbios, bactérias que colonizam as células das raizes formando nódulos (bolinhas) responsáveis por fazer a fixação do nitrogênio atmosférico, atuando como uma de adubação nitrogenada.
“Desta forma, é possível diminuir a adubação nitrogenada, principalmente realizada com uréia, reduzindo riscos como acidificação do solo, contaminação por nitrato e por metais pesados e emissão de gás de efeito estufa”.
Já espécies como Azospirillum e Pseudomonas têm sido recomendadas para melhorar a fertilidade do solo e a disponibilidade de nutrientes. Essas espécies de microrganismos que colonizam a rizosfera atuam solubilizando nutrientes presentes no solo em sua forma insolúvel e inacessível para as plantas, como é o caso do fósforo, minimizando a necessidade de adubação fosfatada, gerando sustentabilidade ao processo produtivo e economia aos produtores.
Outro grupo importante de microrganismos usados na agricultura são espécies capazes de controlar pragas e doenças. Eles são conhecidos como agentes de biocontrole, os mais conhecidos são os gêneros Trichoderma, Bacillus, Beauveria e Metarhizium.
“Muitas espécies de fungos, vírus e bactérias de diferentes cepas estão presentes atualmente nos produtos de nutrição e controle biológico comercializados no Brasil”, afirma Johana. Diferente dos típicos compostos químicos usados no controle de pragas e doenças, os agentes de biocontrole não causam danos ao meio ambiente ou à saúde humana.
Nem todos são benéficos
Isso não quer dizer que não há vilões, algumas poucas espécies de microrganismos causam doenças em plantas e animais, assim como no homem também. Johana explica que, diferente das espécies benéficas, quando ocorre a proliferação dos microrganismos patógenos o efeito é imediato.
“Nesse sentido, o agricultor percebe na hora e por isso é mais comum ouvirmos falar dos microrganismos ruins, que fazem mais ‘barulho’, do que os benéficos, que são mais abundantes, porém, mais discretos”, afirma.
Adicionalmente, Fernando destaca que para evitar o uso de microrganismos que possam causar danos à saúde ambiental e humana é recomendado a aquisição de produtos que sejam registrados pelo MAPA (Ministério da Agricultura, Pecuária e Abastecimento).
Por último, é preciso pontuar que existem espécies benéficas e maléficas para a agricultura, bem como aquelas que não causam efeito algum à planta, estas são conhecidas como comensais. Porém, às vezes, uma espécie comensal pode virar maléfica sob determinadas condições.
O melhor jeito de evitar que proliferem espécies que causam prejuízos à lavoura é manter um solo equilibrado e rico em microrganismos benéficos que são capazes de controlar a multiplicação dos patogênicos através de suas interações.
Nesse sentido, manter práticas agrícolas sustentáveis, reduzindo o uso de fertilizantes e pesticidas químicos, é possível promover um solo mais rico, biodiverso e saudável.
Cuidando do solo
O solo equilibrado, como falamos anteriormente, é essencial para evitar a proliferação de microrganismos maléficos. Nesse sentido, o coordenador técnico da Tradecorp orienta que é preciso adotar técnicas de manejo como a rotação de culturas com uso de mix de plantas de cobertura, plantio direto, uso de adubação orgânica e orgânica-mineral, além da utilização de bioinsumos no sistema produtivo.
Ou seja, todas as tecnologias que promovam aumento da matéria orgânica do solo e a introdução de microrganismos benéficos vão favorecer a comunidade microbiana do solo e o seu equilíbrio.
Para finalizar Johana Perez afirma que a adoção de práticas agrícolas sustentáveis, onde alimentos abundantes são produzidos de maneira eficiente, sem exaurir os recursos naturais do planeta ou contaminar o meio ambiente, é essencial e possível. Para isso, são aplicados os princípios da natureza de formar sistemas agrícolas e pecuários que são autossustentados, assim como a própria natureza.
Veja alguns produtos agrícolas à base de microrganimos clicando neste link.